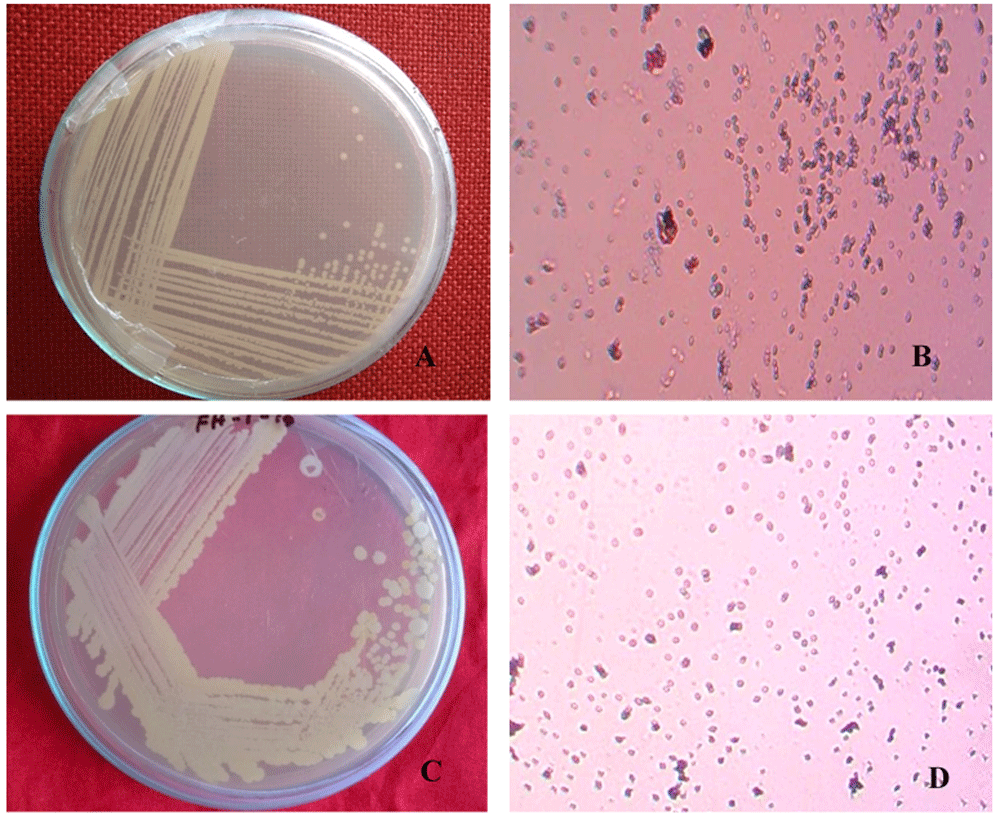
16cea0a1-74a8-4b56-9e64-4f62d6ec57d3_figure1.gif

Keywords
Orange, Black rot, Serratia marcescens, 16S rRNA gene, Biological control
This article is included in the Agriculture, Food and Nutrition gateway.
Orange, Black rot, Serratia marcescens, 16S rRNA gene, Biological control
Orange, Citrus sinensis (L.) Osbeck is the most common and important species among citrus, belonging to the family of Rutaceae. Orange peel has significant contents of vitamin C, dietary fiber, total polyphenols, carotenoids, limonene and dietary minerals (Barros et al., 2012). Conventionally, oranges fruits are used to treat disorders like constipation, pains, indigestion, diarrhea, bronchitis, tuberculosis, cough, cold, obesity, menstrual disorders, angina, hypertension, nervousness, downheartedness and pressure (Milind & Chaturvede, 2012).
Serratia marcescens is an ecologically and genetically diverse pathogenic bacterial species belonging to the family of Enterobacteriaceae (Besler & Little, 2017). S. marcescens may be present as a contamination on the surface of plants or fruits and enter the tissue via natural pores or sores (Wang et al., 2015). Previous reports showed that this bacteria is an opportunist pathogen that causes diseases in humans, such as cystitis (Liu et al., 2004), conjunctivitis (Hume & Willox, 2004) and others.
Serratia marcescens has been reported as a plant pathogen causing yellow vine disease in Citrullus lanatus and Cucurbita pepo (Sikora et al., 2012), soft rot in Capsicum annuum (Gillis et al., 2014), Zea mays whorl rot (Wang et al., 2015), yellow wilt on Helianthus (Ignatov et al., 2016), leaf rot in Cannabis sativa (Schappe et al., 2020) and others. Naturally active plant products are important source of eco-friendly bactericides to control different pathogenic bacteria in vitro and in vivo (Rahman et al., 2014).
To the best of our knowledge, there is no previous report in Bangladesh on black rot disease of Citrus sinensis fruit, including isolating the pathogen and identifying it through molecular approaches. Moreover, biological control of this pathogen by plants extract and antagonistic microbes has not yet been reported.
Therefore, the objective of this study was to isolate and characterize phytopathogenic bacterial strains responsible for black rot of orange, as well as their controlling techniques using biological agents. The 16S rRNA gene sequence analysis and pathogenicity assays were performed to determine the taxonomic position of the isolated bacterial strains. The findings of the current study confirmed that the isolated bacterial pathogen belongs to the species S. marcescens. To the best of our knowledge, this is the first report on S. marcescens associated with black rot of C. sinensis fruits as well reporting ecofriendly control techniques.
In 2018 (September-December), eight black rotted orange fruits were collected from RDA market, Rajshahi, Bangladesh. Bacterial pure colonies were isolated and purified from infected fruits as described previously (Lu & Gross, 2010). Briefly, the infected skin of the fruits were excised with a sterile scalpel and disinfected superficially using 70% alcohol for one minute, sodium hypochlorite for one minute, and finally was rinsed three times in sterile distilled water. The samples were then placed in 100 ml of Luria-Bertani (LB) broth medium and incubated at 37°C overnight. Bacteria was streaked onto a fresh LB agar plate and incubated for 16 hours at 37°C. After that, eight different single colonies were picked up by loop and streaked on fresh medium plate for pure culture. Finally, two pure culture (BS1 and BS2) were selected and preserved in 80% glycerol-water solution at -80°C. The two pure cultures were characterized and identified using different approaches, as below.
The two isolated bacterial strains were observed through several morphological tests. Gram staining and motility of bacteria was conducted as previously described (Zaoti et al., 2018).
The two bacterial isolates (BS1 and BS2) were sub-cultured on LB liquid medium and incubated at 30°C for 16 hours with continuous shaking. Genomic DNA was extracted using an automated DNA extractor (Model: Maxwell 16; Promega, USA) and suspended into TE buffer. Afterwards, quantity and quality of the isolated DNA was checked using NanoDrop Spectrophotometer (Model: ND2000; Thermo Scientific, USA).
The isolated bacterial DNA was amplified using the universal bacterial 16S rRNA gene PCR primers (27F 5’-AGAGTTTGATCCTGGCTCAG3’ and 1492R 5’-CGGTTACCTTGTTACGACTT-3’), as previously described (Srinivasan et al., 2015; Tian et al., 2019); genomic DNA was used as a template. The PCR reaction was performed using the method by Hassan et al. (2018), using hot start green master mix (dNTPs, Buffer, MgCl2, Taq Pol; Cat: M7432; Promega, USA).
A 20 µl reaction mix was used, containing master mixture 10 µl, T DNA (concentration 25-65 ng/µl) 1 µl, each primer (concentration 10-20 pMol) 1 µl and nuclease free water 7 µl. Thermo-cycling parameters were 95°C for 3 minutes, 32 cycles of 95°C for 30 seconds, 48°C for 30 seconds and 72°C for 90 seconds; a final extension step at 72°C was added for 5 minutes, using a PCR machine (Gene Atlas, Model: G2; Astec, Japan). PCR products were run on 1% agarose gel (Cat: V3125; Promega, USA) and visualized under alpha imager UV trans-illumination (Model: mini; Protein Simple, USA) with 0.5% ethidium bromide solution (Cat: H5041; Promega, USA) in 1xTAE buffer (Cat: V4251; Promega, USA) using a1kb DNA ladder (Cat: G5711; Promega, USA). PCR products were purified from the agarose gel, using SV gel and PCR clean up system (Cat: A9281; Promega, USA). Purified PCR products were sequenced commercially by Sanger sequencing (Apical Scientific, Malaysia). Sequences were used in a search using the NCBI BLAST tool. Obtained sequences were submitted to GenBank (see Data availability) and compared with the GenBank database.
A phylogenetic tree was constructed using the Neighbor-Joining method (Saitou & Nei, 1987) based on the 16S rRNA gene showing closest relatives of Serratia marcescens strains isolated from orange samples. The bootstrap consensus tree inferred from 500 replicates is taken to represent the evolutionary history of the taxa analyzed. Branches corresponding to partitions reproduced in less than 50% bootstrap replicates are collapsed. The percentage of replicate trees in which the associated taxa clustered together in the bootstrap test (500 replicates) are shown next to the branches (Felsenstein, 1985). The evolutionary distances were computed using the Maximum Composite Likelihood method (Tamura et al., 2004) and are in the units of the number of base substitutions per site. All ambiguous positions were removed for each sequence pair (pairwise deletion option). Evolutionary analyses were conducted in MEGA X (Kumar et al., 2018).
Virulence competency of the isolates were carried out as previously described by Tafinta et al. (2013). First, healthy, fresh, mature malta, lemon, guava and apple fruits were collected from the RDA market, Rajshahi and were sterilized using water and 70% ethanol. The two isolates BS1 and BS2 were grown on LB agar, suspended in autoclaved distilled water at a concentration of 108 cells/ml (Ignatov et al., 2016) and artificially inoculated into malta, lemon, guava and apple fruits. Autoclaved distilled water was treated as a negative control. All the inoculated fruits showed an oversensitive response after 16 hours. To fulfill Koch’s postulates, bacteria were re-isolated from the artificially infected fruits tissue with symptoms, and characteristics were confirmed based on colony morphology (Abdellatif et al., 2015) on LB agar along with PCR results.
To evaluate antibacterial activities of the isolates, Allium sativum, Hibiscus rosa-sinensis, Ocimum sanctum, Allium cepa, Zingiber montanum and Psidium guajava plants were collected from various places (Kajle and Binodpur villages) in Rajshahi district. Plants extraction was performed using the method described by Kader et al. (2018). Different parts of selected plants (bulb of A. sativum and A. cepa; flowers of H. rosa-sinensis; and leaves of O. sanctum, Z. montanum, and P. guajava) were cut into small pieces, air-dried, and ground by blender to form a fine powder. The dried powder of the selected plants (100gm of each plant) were rinsed in methanol (500ml) using a conical flask and kept in a shaking incubator for 15 days. The liquid contents were pressed through Markin cloth followed by filtration using Whatman no. 1 filter paper. Obtained filtered liquids were dehydrated in vacuo to leave a blackish and sticky mass. The extracts were preserved in a refrigerator at 4°C using glass vials.
For antibacterial screening, BS1 and BS2 bacterial cultures were inoculated on LB agar plates. Subsequently, discs of filter paper (6 mm in diameter) were saturated with the plant extracts at the concentration of 30 µg/disc and were impregnated on the surface of plates. The plates were incubated at 37°C for 16 hours. Inhibition zones were measured with the help of a millimeter scale.
For evaluation of antagonistic effects, five soil bacteria, Rhizobium phaseoli, Rhizobium leguminosarum, Escherichia coli, Bacillus subtilis and Brevibacillus borstelensis were used against isolated bacterial strains (BS1 and BS2). Pure cultures of the soil bacteria were kindly provided by Dr. Md. Salah Uddin, Associate Professor and Director, Microbiology Lab., Department of Genetic Engineering and Biotechnology, University of Rajshahi, Rajshahi, 6205, as the part of a collaboration.
To assess the antagonistic effects, agar well diffusion method was used, as previously described (Valgas et al., 2007). The agar plate’s surface was inoculated by spreading a volume of the microbial inoculum over the entire agar surface. A 6 mm diameter hole was made aseptically with a cork borer. In total, 40 µl/hole bacterial suspension (108 CFU/ml) of the isolates were introduced into the well and were incubated at 37°C for 16 hours. The antibacterial agents diffuse in the LB agar medium that inhibit the growth of the microbial strain tested of soil bacteria against two plant pathogens. The test samples were determined by measuring the diameter of zones of inhibition in term of mm with a transparent scale.
Single and pure colonies were isolated from the infected fruit grown in LB agar medium. The isolated colonies (BS1 and BS2) were round and pure cultures showed cream and white colonies (Figure 1A and C, respectively). Gram stained BS1 and BS2 showed small, rod shaped, pink, motile and Gram-negative colonies (Figure 1B and D).
Isolated bacterial pure colony (A) BS1 and (C) BS2; images taken after 16 hours of incubation at 37°C on LB agar. Gram staining of isolated bacterial pure colony (B) BS1 and (D) BS2; images taken under the light microscope at 100X magnification, showing as Gram negative.
Electrophoretic analysis of the DNA isolated from the bacterial strain revealed sharp high molecular weight of the DNA band, which indicated that the DNA was of good quality and suitable for PCR analysis. From the electrophoretic analysis approximately 1465 bp of PCR product was observed while the negative control did not show any product (Underlying data (Hasan, 2020b)).
The sequences of the total isolates (BS1 and BS2) were compared to Serratia marcescens sequences in GenBank using BLASTN. The partial 16S rRNA gene sequences (accession no. MT912977 and MT912978) were 99.34% and 99.45% (Figure 2A and B), identical to the reference sequence for S. marcescens strains (ID: AY514434.1) and (ID: JX315621.2), respectively.

Phylogenetic tree of (A) BS1 and (B) BS2. The evolutionary history was inferred using the Neighbor-Joining method (Saitou & Nei, 1987). This analysis involved 21 nucleotide sequences. Codon positions included were 1st+2nd+3rd+Noncoding. There were a total of 1494 positions in the final dataset. The scale bar on the rooted tree indicates a 0.50 substitution per nucleotide position.
The pathogenicity assay showed similar morphological characteristics of Serratia marcescens causing black rot symptoms (Figure 3A–E). Isolated bacterial DNA from artificially inoculated malta, lemon, guava and apple fruits showed approximately 1465 bp PCR products (Underlying data (Hasan, 2020d)).

(A) Sweet orange (naturally infected in post-harvest condition), (B) malta (BS1), (C) lemon (BS1), (D) guava (BS2), and (E) apple (BS2) (artificially inoculated); images taken 10 days after inoculation.
The methanol extract of Allium sativum showed the largest (27.33±1.5 mm) and (9.17±0.29 mm) diameter of zone of inhibition against both BS1 and BS2, respectively, at 30 µg/disc concentration. Zingiber montanum leaf extract didn’t show any antibacterial activity against the isolates BS1 and BS2. Data for all plants are given in Figure 4 and in Underlying data (Hasan, 2020e; Hasan, 2020f; Hasan, 2020g).
The largest inhibition zone was found to be 19±1 mm for Rhizobium leguminosarum followed by 14±1 mm for Rhizobium phaseoli against the isolated bacteria. Brevibacillus borstelensis showed no zone of inhibition against the isolated bacteria (images are given in Underlying data (Hasan, 2020i; Hasan, 2020j)). Data are given in Figure 5.
Morpho-molecular identification has been used as universal adequate procedure to detect bacterium through all key phyta. Evaluation of the bacterial 16S rRNA gene, sequencing has developed as a favored genetic method (Clarridge, 2004). Now a days, it has also developed as a significant technique to identify an unfamiliar bacterium to the genus or species level (Sacchi et al., 2002). To distinguish this new disease from the identified rot diseases stated earlier, we propose ‘black rot’ as the common name for the orange disease.
In the present study, the isolated bacterial strains were revealed as gram negative and motile. Tian et al. (2019) reported that Serratia marcescens is a rod-shaped, gram negative bacterium isolated from waste samples which support our present findings. PCR and sequencing was accomplished by 16S rRNA gene amplification for molecular detection of the isolated bacterial strains. Wang et al. (2015) found an identity of 99% to Serratia marcescens strain CPO1 by the BLAST search. Similar result was also reported previously by Altschul et al. (1990). Pathogenicity efficiency of the isolates were confirmed the stains detection using malta, lemon, guava and apple fruits. No significant resistance to this bacterial pathogen was observed in the investigation of the tested fruits. Moreover, Allium sativum plant extract and Rhizobium leguminosarum showed remarkable inhibitory potency against BS1. Villar de Queiroz & Soares de Melo (2006) reported that the strain R3.5 of S. marcescens has an antagonist to P. parasitica in vitro. Present findings revealed the isolates as Serratia marcescens strain, which is responsible for black rot disease of Citrus sinensis fruits.
Bacterial black rot reduces the quantity and quality of the orange and cause chronic losses to the farmers and fruit industries. Advanced molecular approaches along with morphological characterization confirmed the identity of the bacteria as Serratia marcescens. In order to biological control measures of the isolated bacteria, Allium sativum plant extract and Rhizobium leguminosarum bacteria showed promising results. In conclusion, Serratia marcescens causing black rot of orange fruit is a new disease in Bangladesh. Further investigation is needed to better comprehend the biology of the isolates, disease development procedure, and to develop orange varieties resistant or biological control to the bacterial disease in near future.
Serratia marcescens strain BS1 containing 16S rRNA gene and partial sequence on GenBank. Accession number, MT912977: https://www.ncbi.nlm.nih.gov/nuccore/MT912977.1/
Serratia marcescens strain BS2 containing 16S rRNA gene and partial sequence on GenBank. Accession number, MT912978: https://www.ncbi.nlm.nih.gov/nuccore/MT912978.1/
Figshare: Naturally infected postharvest sweet orange fruit showing pure culture and morphological phenotypes, https://doi.org/10.6084/m9.figshare.13108142 (Hasan, 2020a).
This project contains the following underlying data:
- Original, unedited images as shown in Figure 1
Figshare: PCR amplification of 16S rRNA gene generated from bacteria, https://doi.org/10.6084/m9.figshare.13140074 (Hasan, 2020b).
This project contains the following underlying data:
Figshare: Naturally infected and artificially inoculated sample fruits showing symptoms of bacterial black rot, https://doi.org/10.6084/m9.figshare.13109120.v3 (Hasan, 2020c).
This project contains the following underlying data:
- Original, unedited images as shown in Figure 3
Figshare: PCR amplification of 16S rRNA gene generated from bacteria for virulence test, https://doi.org/10.6084/m9.figshare.13140017 (Hasan, 2020d).
This project contains the following underlying data:
- Original, unedited gel images for BS1 isolate, and infected malta, lemon, guava and apple fruits (left to right lanes)
Figshare: Antibacterial activities of methanolic extract of some plant against the isolates BS1 and BS2, https://doi.org/10.6084/m9.figshare.13160348 (Hasan, 2020e).
Figshare: Antibacterial activities of some plants extract against the isolate BS1, https://doi.org/10.6084/m9.figshare.13160615 (Hasan, 2020f).
This project contains the following underlying data:
- Images of zone of inhibition of BS1 for Allium sativum, Hibiscus rosa-sinensis, Ocimum sanctum, Allium cepa, Zingiber montanum and Psidium guajava
Figshare: Antibacterial activities of some plants extract against the isolate BS2, https://doi.org/10.6084/m9.figshare.13160648 (Hasan, 2020g).
This project contains the following underlying data:
- Images of zone of inhibition of BS2 for Allium sativum, Hibiscus rosa-sinensis, Ocimum sanctum, Allium cepa, Zingiber montanum and Psidium guajava
Figshare: Antagonistic activity of soil born bacteria against the isolates BS1 and BS2, https://doi.org/10.6084/m9.figshare.13139981.v1 (Hasan, 2020h).
Figshare: Antagonistic activity of soil born bacteria against the isolates BS1, https://doi.org/10.6084/m9.figshare.13108055 (Hasan, 2020i).
This project contains the following underlying data:
- Images of zone of inhibition of BS1 for Rhizobium phaseoli, Rhizobium leguminosarum, Escherichia coli, Bacillus subtilis and Brevibacillus borstelensis.
Figshare: Antagonistic activity of soil born bacteria against the isolate BS2, https://doi.org/10.6084/m9.figshare.13108061 (Hasan, 2020j).
This project contains the following underlying data:
- Images of zone of inhibition of BS2 for Rhizobium phaseoli, Rhizobium leguminosarum, Escherichia coli, Bacillus subtilis and Brevibacillus borstelensis.
Data are available under the terms of the Creative Commons Attribution 4.0 International license (CC-BY 4.0).
The authors would like to thank Mr. Md. Roushan Ali, MS Research Fellow, Chinese Academy of Sciences, Kunming, China, for software support to analyses the sequences data.
| Views | Downloads | |
|---|---|---|
| F1000Research | - | - |
|
PubMed Central
Data from PMC are received and updated monthly.
|
- | - |
Is the work clearly and accurately presented and does it cite the current literature?
Partly
Is the study design appropriate and is the work technically sound?
Yes
Are sufficient details of methods and analysis provided to allow replication by others?
Partly
If applicable, is the statistical analysis and its interpretation appropriate?
Not applicable
Are all the source data underlying the results available to ensure full reproducibility?
Yes
Are the conclusions drawn adequately supported by the results?
Yes
Competing Interests: No competing interests were disclosed.
Reviewer Expertise: Microbiology
Is the work clearly and accurately presented and does it cite the current literature?
Yes
Is the study design appropriate and is the work technically sound?
Partly
Are sufficient details of methods and analysis provided to allow replication by others?
Yes
If applicable, is the statistical analysis and its interpretation appropriate?
Yes
Are all the source data underlying the results available to ensure full reproducibility?
Yes
Are the conclusions drawn adequately supported by the results?
Partly
Competing Interests: No competing interests were disclosed.
Reviewer Expertise: Plant Pathology, biological control of plant pathogens, identification and characterization.
Is the work clearly and accurately presented and does it cite the current literature?
Yes
Is the study design appropriate and is the work technically sound?
Partly
Are sufficient details of methods and analysis provided to allow replication by others?
Partly
If applicable, is the statistical analysis and its interpretation appropriate?
Yes
Are all the source data underlying the results available to ensure full reproducibility?
Yes
Are the conclusions drawn adequately supported by the results?
Yes
Competing Interests: No competing interests were disclosed.
Reviewer Expertise: Postharvest Biology, Plant pathology, Postharvest pathology, Biocontrol using plant extracts.
Alongside their report, reviewers assign a status to the article:
| Invited Reviewers | |||
|---|---|---|---|
| 1 | 2 | 3 | |
|
Version 2 (revision) 04 Mar 22 |
read | ||
|
Version 1 26 Nov 20 |
read | read | read |
Provide sufficient details of any financial or non-financial competing interests to enable users to assess whether your comments might lead a reasonable person to question your impartiality. Consider the following examples, but note that this is not an exhaustive list:
Sign up for content alerts and receive a weekly or monthly email with all newly published articles
Already registered? Sign in
The email address should be the one you originally registered with F1000.
You registered with F1000 via Google, so we cannot reset your password.
To sign in, please click here.
If you still need help with your Google account password, please click here.
You registered with F1000 via Facebook, so we cannot reset your password.
To sign in, please click here.
If you still need help with your Facebook account password, please click here.
If your email address is registered with us, we will email you instructions to reset your password.
If you think you should have received this email but it has not arrived, please check your spam filters and/or contact for further assistance.
Comments on this article Comments (0)